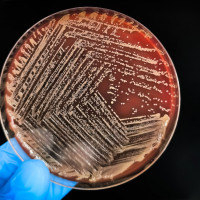
lab agar plate

Animals in Research and Teaching
How is animal research regulated in Australia?
In Australia, all research and teaching that involves the use of live animals must be carried out in accordance with the Australian code of Practice for the care and use of animals for scientific purposes.
What is fetal bovine serum and should it be used?
The commercial production of fetal bovine serum starts with the collection of blood from fetal calves at licensed abattoirs.
How can I avoid animal testing in the products I purchase?
Since most advances in medicine and veterinary health involve some animal research, it is virtually impossible to access medical or veterinary care and avoid using any products that have been developed using animals.
What are the animal welfare issues with chick hatching in schools?
Chick hatching programs occur most commonly at kindergartens and in prep/foundation and lower primary school grades. A chick hatching program is where a school is delivered fertile eggs which hatch a couple of days after arrival.
Does using paintball guns to identify animals cause harm?
Paintball guns are pneumatic firearms driven by compressed gas.
Is cosmetic testing on animals legal in Australia?
Cosmetic products include make-up and skin-care products as well as soaps, shower gels, deodorants, shampoos, toothpastes, some sunscreens and similar products. Testing a finished cosmetic product on animals is not permitted in Australia.
Why are animals used in research?
A diverse range of animal species are used in research but the vast majority are rats, mice and fish; guinea pigs, rabbits, cattle, sheep, horses, dogs, cats and other animals are also used.
What is the RSPCA’s view of the use of animals in research?
Millions of animals are used in research and teaching in Australia each year. It is essential that the sentience of these animals is recognised and that their welfare is considered a high priority.
What are the welfare issues with animals used in research?
The use of animals in research poses many welfare risks including those associated with housing, nutrition, social groupings, handling practices, interventions and fate of the animals. These risks may result in pain, fear, physical injury, disease, anxiety and distress resulting in suffering and/or reduced ability to function normally.
What are the 3Rs in animal research?
The 3Rs (Three Rs) of replacement, reduction and refinement have guided research involving animals through the use of humane principles around the world. The 3Rs have been adopted in various ways through policy, guidelines and legislation.